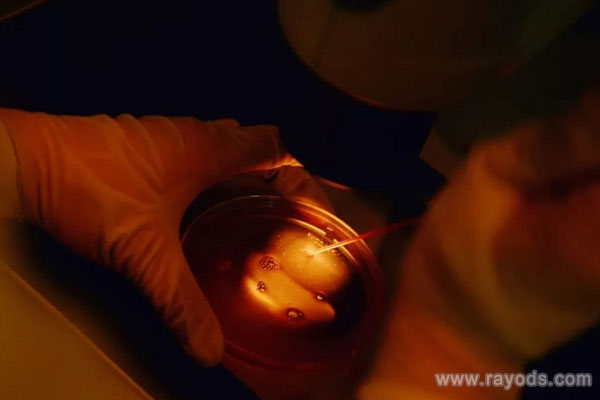

俄罗斯阿瓦彼得医院做试管婴儿需要多长时间?
- 试管婴儿百科
- 2025-12-23 09:59
可能需要两个月左右的时间,试管婴儿本就是一个时间周期较长的辅助生殖手术,而俄罗斯的阿瓦彼得医院是一所综合实力极强且试管成功率非常高的医院,根据此院所提供的相关数据来看,在此院做试管婴儿使用的平均时间就为两个月左右。
但此数据只是阿瓦彼得医院提供的平均试管所需时间而已,并不是所有人在此院做试管花费的时间都是2个月,因为做试管婴儿所需时间是根据以下影响因素而定的:
1、患者的卵巢功能与年龄
促排卵是试管婴儿中非常重要的一个步骤,而不同患者在此步骤所消耗的时间是不一样的,因为不同年龄和不同的卵巢功能所使用的促排卵方案不一样,而有的促排方案可能需要两个与,而有的促排方案可能只需15天。
2、卵子与精子的质量
卵子与精子的质量也是影响试管婴儿所需时间的一大因素,因为卵子与精子结合的时间却决于精卵的质量,只有质量较高的的精卵子,结合所花的时间才会更短,反之时间则会更长。
3、患者的胚胎移植成功率
胚胎移植手术并不可以连续做,若失败之后则需要等待一段时间才能做,所以患者的胚胎移植成功率越高,移植手术的次数可能就会越少,而所需时间自然就会更少,反之则会需要更多的时间。
发表评论